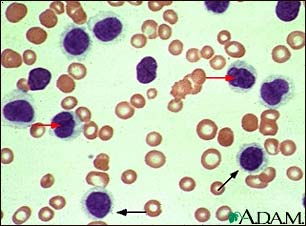
Hairy cell leukemia - microscopic view

Health Library
Hairy cell leukemia
Leukemic reticuloendotheliosis; HCL; Leukemia - hairy cell
Hairy cell leukemia (HCL) is an unusual cancer of the blood. It affects B lymphocyte cells, a type of white blood cell.
Images

I Would Like to Learn About:
Causes
HCL is caused by the abnormal growth of certain B cells. The cells look "hairy" under the microscope because they have fine projections extending from their surface.
HCL usually leads to a low number of normal blood cells.
The cause of this disease is unknown. Certain genetic changes in the cancer cells may be the cause. It affects men more often than women. The average age of diagnosis is 55.
Symptoms
Symptoms of HCL may include any of the following:
- Easy bruising or bleeding
- Heavy sweating (especially at night)
- Fatigue and weakness
- Feeling full after eating only a small amount
- Recurrent infections and fevers
- Pain or fullness in the upper left belly (enlarged spleen)
- Swollen lymph glands
- Weight loss
Exams and Tests
During a physical exam, your health care provider may be able to feel a swollen spleen or liver. An abdominal CT scan or ultrasound may be done to evaluate this swelling.
Blood tests that may be done include:
- Complete blood count (CBC) to check low levels of white and red blood cells, as well as platelets.
- Blood tests and a bone marrow biopsy to check for hairy cells.
Treatment
Treatment may not be needed for the early stages of this disease. Some people may need an occasional blood transfusion.
If treatment is needed because of very low blood counts, chemotherapy medicines can be used.
In most cases, chemotherapy can relieve the symptoms for many years. When the signs and symptoms go away, you are said to be in remission.
Removing the spleen may improve blood counts, but is unlikely to cure the disease. Antibiotics can be used to treat infections. People with low blood counts may receive growth factors and, possibly, transfusions.
Outlook (Prognosis)
Most people with HCL can expect to live 10 years or longer after diagnosis and treatment.
Possible Complications
The low blood counts caused by hairy cell leukemia can lead to:
- Infections
- Fatigue
- Excessive bleeding
When to Contact a Medical Professional
Contact your provider if you have major bleeding. Also contact your provider if you have signs of infection, such as a persistent fever, cough, or general ill feeling.
Prevention
There is no known way to prevent this disease.
References
National Cancer Institute website. Hairy cell leukemia treatment (PDQ) health professional version. www.cancer.gov/types/leukemia/hp/hairy-cell-treatment-pdq. Updated September 20, 2024. Accessed December 3, 2024.
Nasr MR, Hutchison RE. Leukocytic disorders. In: McPherson RA, Pincus MR, eds. Henry's Clinical Diagnosis and Management by Laboratory Methods. 24th ed. Philadelphia, PA: Elsevier; 2022:chap 34.
Ravandi F. Hairy cell leukemia. In: Hoffman R, Benz EJ, Silberstein LE, et al, eds. Hematology: Basic Principles and Practice. 8th ed. Philadelphia, PA: Elsevier; 2023:chap 77.
BACK TO TOPReview Date: 6/17/2024
Reviewed By: Todd Gersten, MD, Hematology/Oncology, Florida Cancer Specialists & Research Institute, Wellington, FL. Review provided by VeriMed Healthcare Network. Also reviewed by David C. Dugdale, MD, Medical Director, Brenda Conaway, Editorial Director, and the A.D.A.M. Editorial team.
![]() | A.D.A.M., Inc. is accredited by URAC, for Health Content Provider (www.urac.org). URAC's accreditation program is an independent audit to verify that A.D.A.M. follows rigorous standards of quality and accountability. A.D.A.M. is among the first to achieve this important distinction for online health information and services. Learn more about A.D.A.M.'s editorial policy, editorial process and privacy policy. A.D.A.M. is also a founding member of Hi-Ethics. This site complies with the HONcode standard for trustworthy health information: verify here. |
The information provided herein should not be used during any medical emergency or for the diagnosis or treatment of any medical condition. A licensed medical professional should be consulted for diagnosis and treatment of any and all medical conditions. Links to other sites are provided for information only -- they do not constitute endorsements of those other sites. No warranty of any kind, either expressed or implied, is made as to the accuracy, reliability, timeliness, or correctness of any translations made by a third-party service of the information provided herein into any other language. © 1997- 2025 A.D.A.M., a business unit of Ebix, Inc. Any duplication or distribution of the information contained herein is strictly prohibited.

